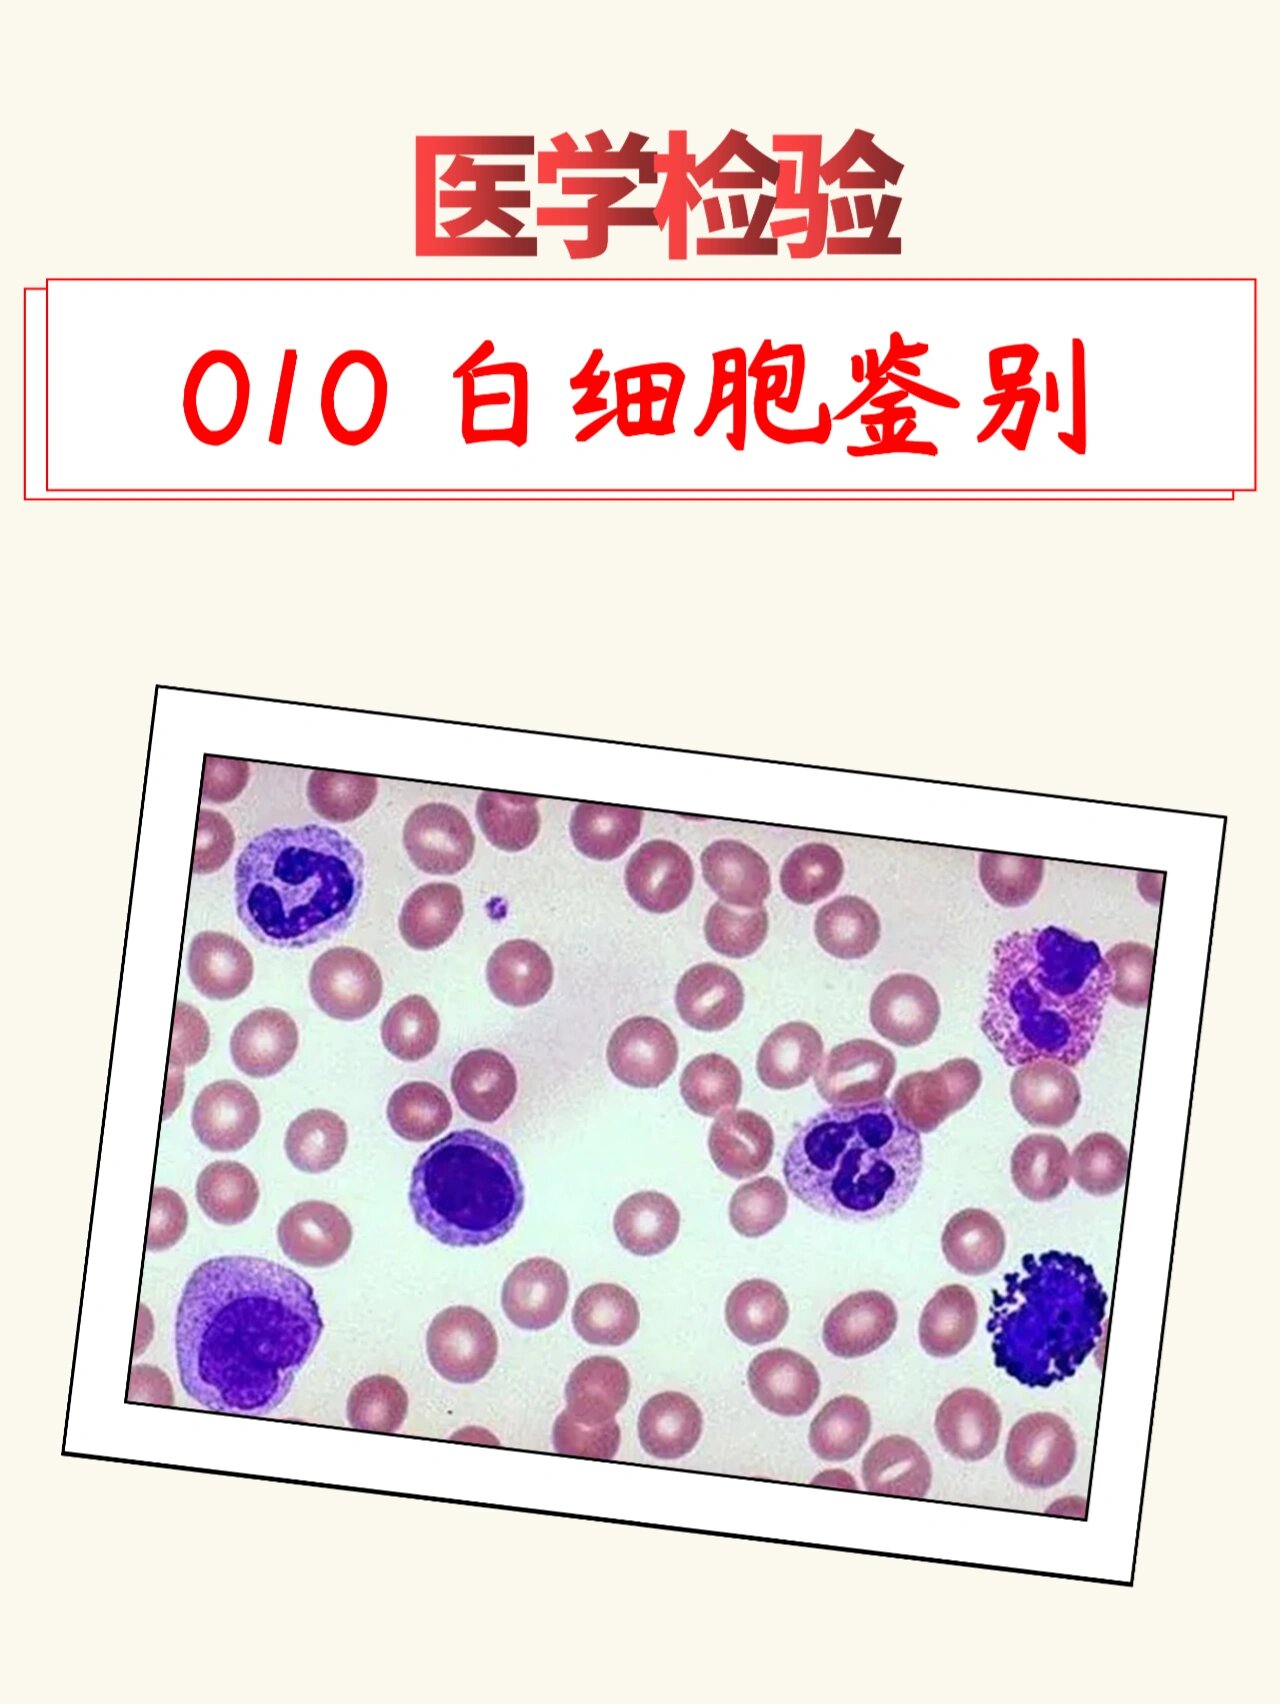
分不清各种白细胞?
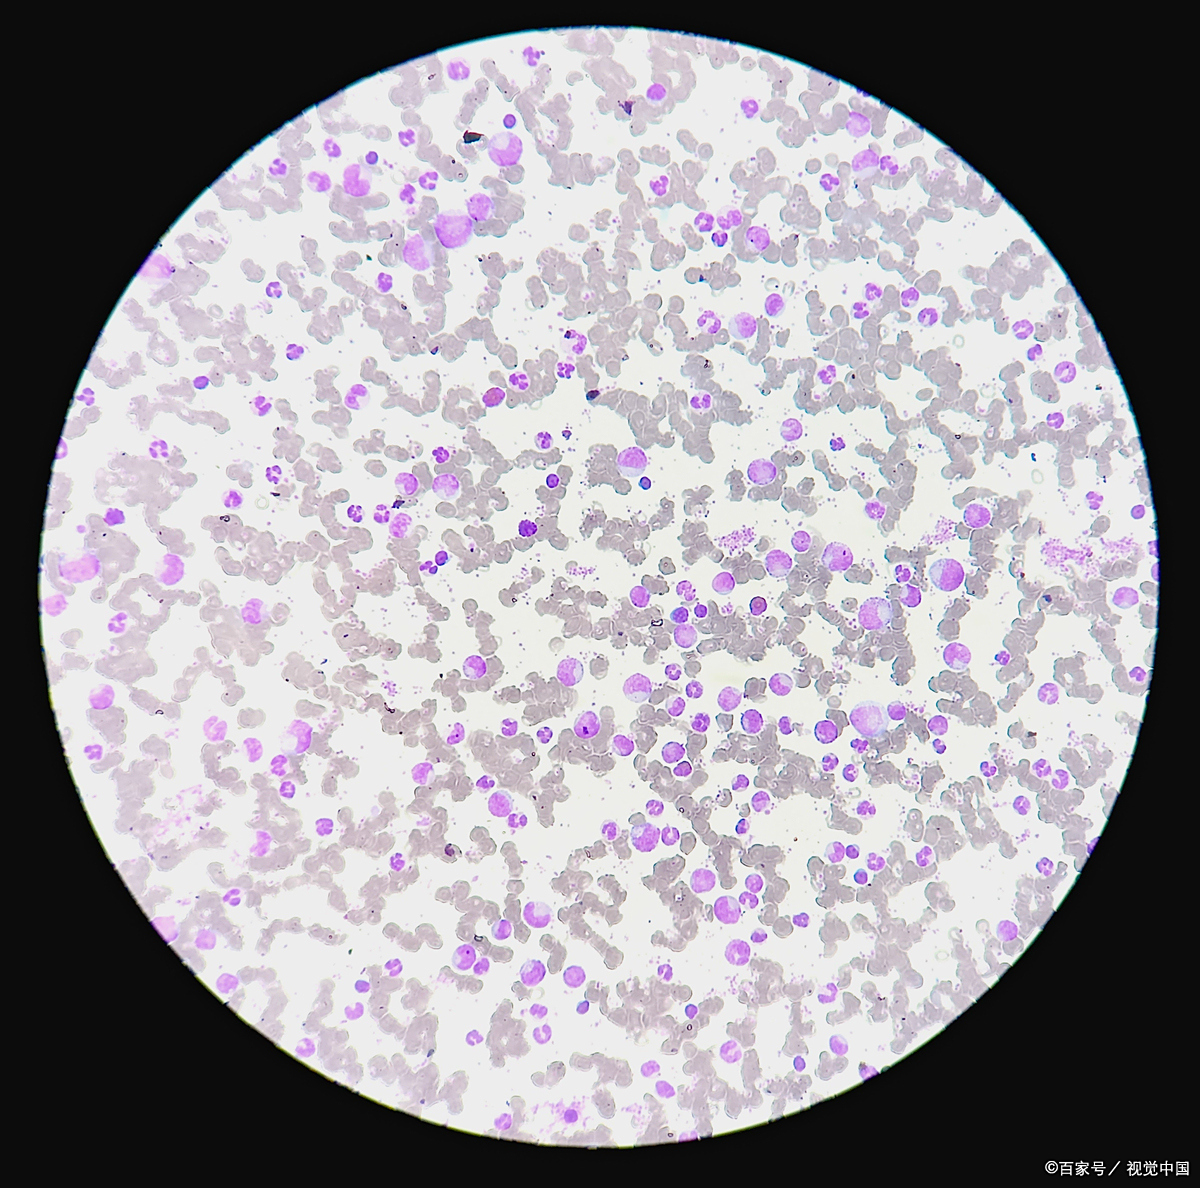
镜检白细胞高应该怎么处理

正常白细胞

白细胞正常形态绘图
图片尺寸1920x2560
白细胞家族大揭秘:形态与功能的奇妙对应
图片尺寸1080x732
尿检—白细胞
图片尺寸1920x2560
白细胞计数:236×10的9次方每升
图片尺寸3472x4624
白细胞6.1正常吗?
图片尺寸1242x1660
犬猫血常规白细胞形态种类.需要原图可以主页#领取资料 #宠物
图片尺寸1080x1526
请你看白细胞
图片尺寸1080x1081 图片尺寸900x1200
图片尺寸900x1200
白细胞计数:236×10的9次方每升
图片尺寸3472x4624
白细胞是身体的"免疫警察",正常范围是每微升血液
图片尺寸750x1000
尿检—白细胞
图片尺寸1920x2560
白细胞是身体的守护将军,但你对它的了解又有多少呢?
图片尺寸1920x1440
分不清各种白细胞?
图片尺寸1280x1704
白细胞如何与寄生虫搏斗,守护身体健康?
图片尺寸1080x1440
你身体里的免疫卫士
图片尺寸1080x1440
镜检白细胞高应该怎么处理
图片尺寸1200x1188
白细胞如何守护你的健康?显微镜下揭示他们的努力与勇敢
图片尺寸720x960
白细胞的作用到底有多大. #科普 #白细胞 #白细胞吞噬细菌
图片尺寸1080x1920
白细胞计数:236×10的9次方每升
图片尺寸3472x4624
孩子发烧总是让家长揪心不已,而拿到血常规报告,看到白细胞正常时,更
图片尺寸1200x1600





 图片尺寸900x1200
图片尺寸900x1200
















 图片尺寸900x1200
图片尺寸900x1200